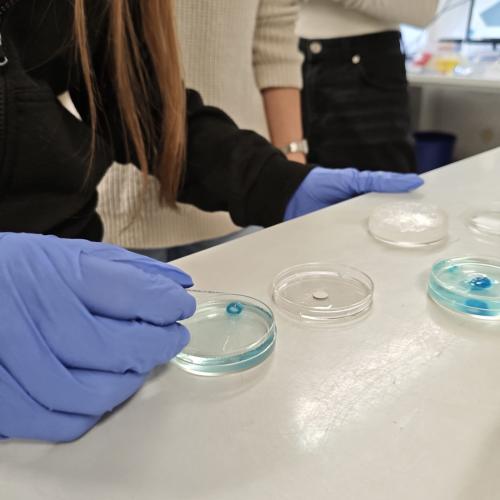
3D_2

WPF Science: Live-Einblick in den 3D-Biodruck
Die WPF Science Gruppe besuchte das 3D-Biodruck Labor der Medizinischen Universität Innsbruck. Dort wird an einer visionären Technologie gearbeitet: dem Druck von lebendem Gewebe.
Die Highlights:
- Innovation: Wir erfuhren, wie gedrucktes Tumorgewebe dabei hilft, Medikamente ganz ohne Tierversuche zu testen.
- Technik hautnah: Neben der Besichtigung des Labors konnten wir den Biodrucker in Aktion erleben.
- Selbst ausprobieren: Besonders spannend war es, die Steuerung und die Materialien im Labor nicht nur theoretisch zu verstehen, sondern im Rahmen des Workshops auch selbst auszuprobieren, wie man mit der Technik umgeht.
Ein faszinierender Vormittag, der uns gezeigt hat, wie Medizin und Technik die Zukunft der Krebsforschung verändern!